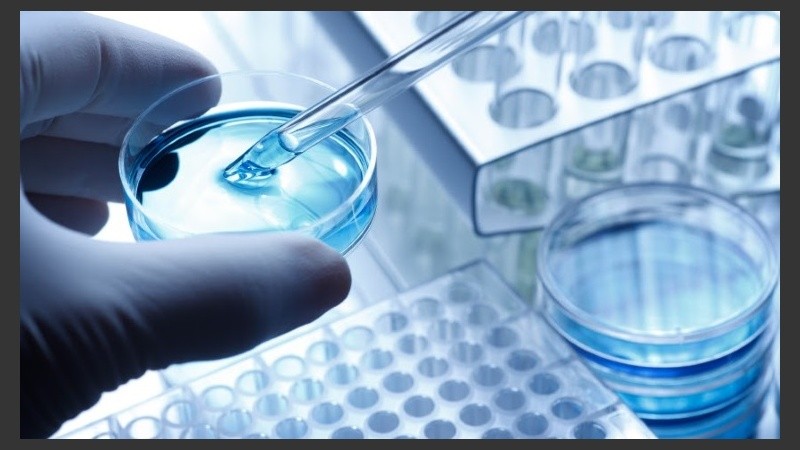
El plasma rico en plaquetas está en auge en su utilización en mejorar los órganos sexuales.

La medicina regenerativa es una rama especializada en la reparación de tejidos dañados o cuya función es anómala, mediante técnicas que utilizan tejidos autólogos (sangre o células de uno mismo) que promueven la curación y reparación del tejido afectado. Si bien se la considera la medicina del futuro, se utiliza ampliamente en la actualidad, y es muy efectiva para la prevención, publica Télam.
En todos los tejidos del cuerpo se suceden procesos que hacen que las células se degeneren o dañen, lo que produce el recambio celular. En las personas mayores estos procesos suceden de forma más lenta y con menor capacidad para regenerar.
Esto es regla en todos los tejidos del cuerpo, se puede observar en el cabello, músculos, páncreas, próstata, etc. Las células cutáneas, por ejemplo, sufren arrugas, la piel se afina y su calidad se deteriora. Las funciones sexuales también se ven deterioradas, lo que afecta la calidad de vida. Así, en las articulaciones, el tiempo produce desgaste de las células del cartílago lo que genera artrosis y lleva a la deformación con dolor asociado.
Este tipo de tratamientos no solo sirve en aquellos pacientes que ya padecen artrosis o desgaste articular, por ejemplo, sino que se puede realizar como prevención en aquellos pacientes con mínimo dolor o sin dolor para prevenir el desgaste del tiempo tanto en articulaciones como cara o cabello, por ejemplo.
Hoy en Estados Unidos se están utilizando dos técnicas para la regeneración de tejidos asociadas a la realización de ejercicios y una alimentación adecuada.
La primera es el Plasma Rico en Plaquetas (PRP), que si bien es conocida por su aplicación en estética para el rejuvenecimiento o regeneración de la piel y del cabello, se utiliza en la actualidad para regenerar articulaciones, tendones, ligamentos y para las células de los órganos sexuales.
Está técnica consiste en extraer sangre a una persona, y, a través de distintos métodos de centrifugación, obtener un concentrado de plaquetas. Dentro de la pared de las plaquetas se encuentran los factores de crecimiento que son los que producen la regeneración de los tejidos. Este concentrado se inyecta en las zonas donde que se quiere estimular la reparación de las células (articulaciones, piel, cabello, entre otros). Los factores inyectados producen nuevos vasos sanguíneos y atraen a su vez más células que colaboran con el proceso de regeneración.
El PRP al estimular, por ejemplo, las células que producen cartílago en las articulaciones, deviene en la formación de nuevo cartílago que puede mejorar la función y estado articular. Este tipo de tratamientos suele repetirse en tres ocasiones, con intervalos de 30 días, para generar el estímulo suficiente para la reparación de los distintos tejidos.
El plasma rico en plaquetas está en auge en su utilización en mejorar los órganos sexuales.
La segunda y más moderna técnica son las Células Madres o Stem Cells. Consiste en tomar muestras de médula ósea (Bone Narrow) o de grasa (Fat Grapth) donde se encuentran células madres adultas con el potencial de convertirse en células que hayan sido dañadas, de cualquier parte del cuerpo.
El uso de las stem cells en medicina es cada vez mayor. En el campo musculo-esquelético en particular, se utiliza hace años con evidencia científica de que reduce el dolor y mejora el funcionamiento de articulaciones y ligamentos.
Las células madres adultas, al ser inyectadas en una articulación, tienen la capacidad de convertirse en condrocitos (células de cartílago). Siempre las células madres tienen que trabajar con factores de crecimiento para ser más efectivas. Por ejemplo, si quisiéramos reparar una pared debemos utilizar ladrillos -células madres que proporcionan la materia prima para sostener la pared- y obreros que manipulen esos ladrillos, o sea plasma rico en plaquetas ya que los factores de crecimiento son los que estimulan la reparación de las células. Este novedoso tratamiento se realiza una o dos veces al año.
Tanto el plasma rico en plaquetas como las stem cells sirven para prevenir la artrosis en aquellos pacientes que no presentan síntomas. Se puede utilizar en pacientes con artrosis leves o moderadas para producir la regeneración de cartílago y restituir la función articular y eliminar el dolor en aquellos pacientes que lo presentan. Como recuperan la articulación y mejoran el funcionamiento se presentan como alternativa para evitar la cirugía y la colocación de prótesis.
(*) Especialista en Medicina Familiar, Medicina Musculo-esquelética y Medicinas regenerativas. Presidente de la Asociación Latinoamericana de medicina Músculo-esquelética (LAOM).